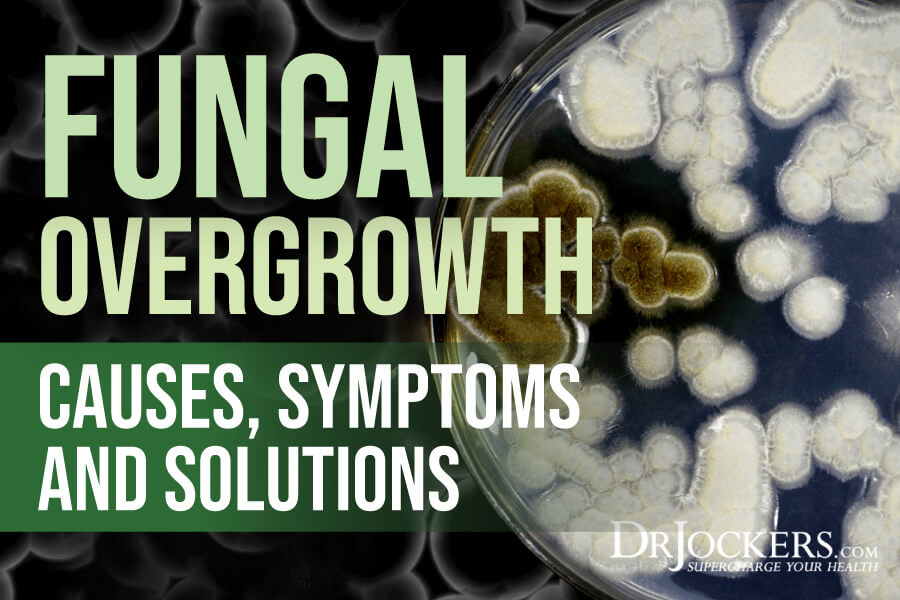
drjockers.com

|
|---|
Become a Patron!
You are using an out of date browser. It may not display this or other websites correctly.
You should upgrade or use an alternative browser.
You should upgrade or use an alternative browser.
Jimi's Daily Health Articles
- Thread starter Jimi
- Start date
Loss + Trauma Associated With Topical Steroid Withdrawal w/ Kathryn Tullos


162: Loss + Trauma Associated With Topical Steroid Withdrawal w/ Kathryn Tullos
Topical Steroid Withdrawal (TSW) can cause chaos in the body. But it can also begin to affect one's emotional health, as well as their relationships.
www.skinterrupt.com
Vaccine trial FAILURE: Second AstraZeneca COVID-19 volunteer develops rare neurological condition

 www.naturalhealth365.com
www.naturalhealth365.com

COVID-19 Vaccine Trial Failure Again | NaturalHealth365
(NaturalHealth365) AstraZeneca COVID-19 vaccine trial reports about another victim of neurological problems after receiving the vaccine.
 www.naturalhealth365.com
www.naturalhealth365.com
Hi Jimi, It’s no secret that eating well reduces your risk of getting sick. COVID-19 has made immune health more important than ever, but it’s also made it much harder to stay healthy. Financial stress, worries about friends and family members, and social isolation often make people reach for comfort foods and sugary treats. Unfortunately, these are the worst foods for your immune health. To make it easier for you to make healthy choices during these trying times, we published a free ebook on our site that contains essential information like:
In this recipe book, you’ll find recipes for beverages, soups and stews, entrées, condiments, and healthy treats and snacks! >> Click here to get your copy of Quarantine Cuisine: Easy, Nourishing Recipes To Support Your Immune System (no email required to download) And be sure to write back to let us know which recipe you like best! To your health always, |
Wildfires And Air Quality: What You Need To Know

 myersdetox.com
myersdetox.com

Wildfires And Air Quality: What You Need To Know
Even if you don't live in an area that's experiencing wildfires, the toxic emissions that they release may still be reaching you. In fact, large wildfires can increase air pollution over thousands of square miles. For this reason, it’s crucial that you take steps to protect yourself and your...
7-Day Liver Cleanse: Better Energy, Skin and Mental Clarity

 drjockers.com
drjockers.com

7-Day Liver Cleanse: Better Energy, Skin and Mental Clarity
Everyday we are exposed to a tremendous load of toxins that stress our liver. A liver cleanse may be what you need to turn around your health
Top 5 Blood Tests For Inflammation

 drjockers.com
drjockers.com

Top 5 Blood Tests For Inflammation
Inflammation is present in almost every chronic disease. I consider these 5 blood tests for inflammation to be the most effective.
Almond Butter Keto Bread

 drjockers.com
drjockers.com

Almond Butter Keto Bread
If you are looking for a great low-carb bread than try this! You will love the flavor and texture of this almond butter keto bread.
Fungal Overgrowth: Causes, Symptoms & Solutions

 drjockers.com
drjockers.com

Fungal Overgrowth: Causes, Symptoms & Solutions
Fungal overgrowth is the overgrowth of fungi, most commonly, the yeast Candida in your body that leads to gut flora imbalance and symptoms.
| ||||||
Hi Jimi,
If you really want to boost your immune system...The first thing you’ll need to do is strengthen and rejuvenate your liver!
Your liver helps your body by providing it with energy, fighting off infections and toxins, helping clot the blood, regulating hormones and much, much more.
One of your livers' many jobs is to capture and disarm any harmful bacteria or viruses trying to enter your body through your gut.
Because of its wide-ranging responsibilities, your healthy liver can come under attack by viruses, toxic substances, contaminants and diseases.
Lifestyle can factor into and affect the overall wellbeing of this major organ.
Unfortunately, most people's liver has been compromised by...
In this new ebook you'll find out why so many people are getting Fatty Liver Disease as well as 24 all-natural solutions for helping you get rid of it quickly.
Like a natural liver cleanser that's been used safely and successfully for over 2,000 years. This remedy is easy to find, inexpensive, and simple to use so...
Why not try it?
Your liver will love you for it!
To your liver health,
The VegHealth Team
P.S.- Claiming a copy of the Ebook will also save your seat for the free, online Fatty Liver Docu-Class — Did you know Fatty Liver Disease is the hidden cause of autoimmune disorders, cancer, diabetes, heart disease and even skin issues?? Save your seat now to learn more!
If you really want to boost your immune system...The first thing you’ll need to do is strengthen and rejuvenate your liver!
Your liver helps your body by providing it with energy, fighting off infections and toxins, helping clot the blood, regulating hormones and much, much more.
One of your livers' many jobs is to capture and disarm any harmful bacteria or viruses trying to enter your body through your gut.
Because of its wide-ranging responsibilities, your healthy liver can come under attack by viruses, toxic substances, contaminants and diseases.
Lifestyle can factor into and affect the overall wellbeing of this major organ.
Unfortunately, most people's liver has been compromised by...
- Prescription and over the counter medications
- Smoking and Alcohol
- Sugar and artificial sweeteners
- Artificial colors and flavors
- Air and water pollution
- Poor diet and lack of exercize
In this new ebook you'll find out why so many people are getting Fatty Liver Disease as well as 24 all-natural solutions for helping you get rid of it quickly.
Like a natural liver cleanser that's been used safely and successfully for over 2,000 years. This remedy is easy to find, inexpensive, and simple to use so...
Why not try it?
Your liver will love you for it!
To your liver health,
The VegHealth Team
P.S.- Claiming a copy of the Ebook will also save your seat for the free, online Fatty Liver Docu-Class — Did you know Fatty Liver Disease is the hidden cause of autoimmune disorders, cancer, diabetes, heart disease and even skin issues?? Save your seat now to learn more!
| ||
| ||
|
Beer Compounds Improve Metabolic Syndrome
By Chauncey Crandall, M.D.
Compounds derived from hops — the flowers that give beer a bitter flavor — can likely improve cognitive and other functions in people with metabolic syndrome, according to new research at Oregon State University and Oregon Health & Science University.
Metabolic syndrome is a combination of health problems such as obesity, low "good" cholesterol, high blood pressure, and elevated glucose levels. They are linked to cardiovascular disease and Type 2 diabetes.
Special: Health Secrets Exposed — How to Save Yourself and Your Loved Ones
The research, led by Fred Stevens and Jacob Raber, focused on xanthohumol (XN), a prenylated flavonoid from hops, and two of its hydrogenated derivatives: DXN and TXN.
Using a mouse model, tests showed that XN and its hydrogenated derivatives improve glucose intolerance and insulin resistance and sensitivity to leptin — a hormone that makes you feel full when you've eaten enough.
"Our findings with rodents suggest that that it may be possible to reduce or even prevent learning and memory impairments through a derivative of the same chemical compound found in beer," said Raber.
By Chauncey Crandall, M.D.
Compounds derived from hops — the flowers that give beer a bitter flavor — can likely improve cognitive and other functions in people with metabolic syndrome, according to new research at Oregon State University and Oregon Health & Science University.
Metabolic syndrome is a combination of health problems such as obesity, low "good" cholesterol, high blood pressure, and elevated glucose levels. They are linked to cardiovascular disease and Type 2 diabetes.
Special: Health Secrets Exposed — How to Save Yourself and Your Loved Ones
The research, led by Fred Stevens and Jacob Raber, focused on xanthohumol (XN), a prenylated flavonoid from hops, and two of its hydrogenated derivatives: DXN and TXN.
Using a mouse model, tests showed that XN and its hydrogenated derivatives improve glucose intolerance and insulin resistance and sensitivity to leptin — a hormone that makes you feel full when you've eaten enough.
"Our findings with rodents suggest that that it may be possible to reduce or even prevent learning and memory impairments through a derivative of the same chemical compound found in beer," said Raber.
Hi ,
We can't believe the 2020 Plant Fit Summit starts in less than two days!
To "warm up" we've decided to share two of our most popular interviews from 2018.
Click here to watch the inspiring story of a couple who thought they may lose each other (she was obese and he had stage four cancer)
Here's what others said about this interview:
Nancy W.: "This story is amazing! Everybody should listen and learn."
Jill B.: "Great story and so inspirational - what great advocates."
Rick M.: "Wow! What an inspiring interview. I will share it everywhere. I'm looking forward to the whole summit. I always call my health journey "my bumpy road back to health" because I have had lots of slips and setbacks. So my advice to everyone is don't beat yourself up, just get back on the program and appreciate the progress you have made!"
And Rick is so right! It's a bumpy road, there may be setbacks but we can pick ourselves back up and move forward - even during tumultuous times like these. But you need the right strategies, inspiration and knowledge and that's exactly what you'll get when you join the 2020 summit.
Each of the 9 days has a specific focus where you get to learn from 4-5 speakers (think of it like getting the highlights of nine separate conferences only that you can watch it all from the comfort of your home without all the hassle or stress). Here are the daily topics:
Click here to check out the full line-up and reserve your complimentary spot now.
See you there!
Thank you,
Tobi & Luke
P.S. We'll email you warm-up #2 tomorrow so look out for our next email. In the meantime here's an exclusive preview of this year's summit.
We can't believe the 2020 Plant Fit Summit starts in less than two days!
To "warm up" we've decided to share two of our most popular interviews from 2018.
Click here to watch the inspiring story of a couple who thought they may lose each other (she was obese and he had stage four cancer)
Here's what others said about this interview:
Nancy W.: "This story is amazing! Everybody should listen and learn."
Jill B.: "Great story and so inspirational - what great advocates."
Rick M.: "Wow! What an inspiring interview. I will share it everywhere. I'm looking forward to the whole summit. I always call my health journey "my bumpy road back to health" because I have had lots of slips and setbacks. So my advice to everyone is don't beat yourself up, just get back on the program and appreciate the progress you have made!"
And Rick is so right! It's a bumpy road, there may be setbacks but we can pick ourselves back up and move forward - even during tumultuous times like these. But you need the right strategies, inspiration and knowledge and that's exactly what you'll get when you join the 2020 summit.
Each of the 9 days has a specific focus where you get to learn from 4-5 speakers (think of it like getting the highlights of nine separate conferences only that you can watch it all from the comfort of your home without all the hassle or stress). Here are the daily topics:
- Boost your immunity & protect your health
- Enjoy new vitality by restoring your hormonal balance
- Master your mind – the key to achieving your goals
- How to use nutrition and movement for abundant energy
- Overcoming stress and inflammation for vibrant health
- The truth about weight loss and diabetes
- The Gut – Brain Connection
- Detox with simple hacks in your kitchen and life
- The origins of cancer – and what to do about it
Click here to check out the full line-up and reserve your complimentary spot now.
See you there!
Thank you,
Tobi & Luke
P.S. We'll email you warm-up #2 tomorrow so look out for our next email. In the meantime here's an exclusive preview of this year's summit.
| ||
| ||
|
|
Dr. Chauncey Crandall, M.D. writes:
The media often portray heart disease as a man's problem, but new research suggests that women's blood vessels actually age faster than men's do.
The new study found that blood pressure started increasing in women as early as the third decade of life, and it continued to rise higher than blood pressure in men throughout their life span. The researchers said that this early change in blood pressure sets the stage for different types of cardiovascular disease later in life.
Special: How to Fix Your Blood Pressure (Do This Every Day)
"Women actually start out with a lower blood pressure," explained study senior author Dr. Susan Cheng, director of public health research at the Smidt Heart Institute at Cedars-Sinai Medical Center in Los Angeles.
"If you think of it like a race, women start behind the starting line. So, when they get to the finish line, women have gotten there by running faster and harder, [which] causes more stress to their systems," she added.
The study included more than 32,000 people ranging in age from 5 to 98. Over four decades, the researchers gathered almost 145,000 blood pressure measurements.
The investigators found that women showed signs of higher blood pressure much earlier in life than men.
The author of an accompanying editorial, Dr. Nanette Wenger, explained, "What this study says is that blood pressure may be really important for women. The higher trajectory starts early and is a continuous rise. Women should know their blood pressure, and they should know when it changes."
The media often portray heart disease as a man's problem, but new research suggests that women's blood vessels actually age faster than men's do.
The new study found that blood pressure started increasing in women as early as the third decade of life, and it continued to rise higher than blood pressure in men throughout their life span. The researchers said that this early change in blood pressure sets the stage for different types of cardiovascular disease later in life.
Special: How to Fix Your Blood Pressure (Do This Every Day)
"Women actually start out with a lower blood pressure," explained study senior author Dr. Susan Cheng, director of public health research at the Smidt Heart Institute at Cedars-Sinai Medical Center in Los Angeles.
"If you think of it like a race, women start behind the starting line. So, when they get to the finish line, women have gotten there by running faster and harder, [which] causes more stress to their systems," she added.
The study included more than 32,000 people ranging in age from 5 to 98. Over four decades, the researchers gathered almost 145,000 blood pressure measurements.
The investigators found that women showed signs of higher blood pressure much earlier in life than men.
The author of an accompanying editorial, Dr. Nanette Wenger, explained, "What this study says is that blood pressure may be really important for women. The higher trajectory starts early and is a continuous rise. Women should know their blood pressure, and they should know when it changes."
Hugs for Health: Your Way to a Stronger Immune System


Hugs for Health: Your Way to a Stronger Immune System
Share Primal Musings: 231 Shares Facebook 231 Twitter LinkedIn Email Print More Hug Your Way to a Stronger Immune System […]
primalmusings.com
Dry Eyes May Be Helped with Nutrients
PARIS – In a study conducted at the Lariboisière Hospital with the results published in the Journal of French Ophthalmology scientists sought to determine if dry eye symptoms could be improved with polyunsaturated fatty acids (PUFAS) added to the diet.
Seventy one patients with mild to moderate dry eye symptoms were randomly assigned to receive a supplement containing polyunsaturated fatty acids or placebo capsules, twice a day for 6 months.
For participants taking the supplement there was an improvement that reached the threshold of significance for various dry eye symptoms along with improvements in skin quality and emotional condition, which were improved 61% with treatment versus 36% with placebo.
According to the researcher’s published conclusions:
“This double-masked pilot study shows that PUFAs seem to be an interesting tool to alleviate the symptoms related to dry eye syndrome.”
The American Heart Association recommends eating tofu and other forms of soybeans, canola, walnut and flaxseed, and their oils to add PUFAS to your diet.
If you suffer from dry eyes you might want to consider adding these foods to your diet.
Have a healthy day,
PARIS – In a study conducted at the Lariboisière Hospital with the results published in the Journal of French Ophthalmology scientists sought to determine if dry eye symptoms could be improved with polyunsaturated fatty acids (PUFAS) added to the diet.
Seventy one patients with mild to moderate dry eye symptoms were randomly assigned to receive a supplement containing polyunsaturated fatty acids or placebo capsules, twice a day for 6 months.
For participants taking the supplement there was an improvement that reached the threshold of significance for various dry eye symptoms along with improvements in skin quality and emotional condition, which were improved 61% with treatment versus 36% with placebo.
According to the researcher’s published conclusions:
“This double-masked pilot study shows that PUFAs seem to be an interesting tool to alleviate the symptoms related to dry eye syndrome.”
The American Heart Association recommends eating tofu and other forms of soybeans, canola, walnut and flaxseed, and their oils to add PUFAS to your diet.
If you suffer from dry eyes you might want to consider adding these foods to your diet.
Have a healthy day,
|
|
You enter your supermarket, after promising yourself that you’re going to start making better choices.
You get to the egg section…
Cage-free…
Hormone free…
Vegetarian...
Organic…
Pasture raised…
Non-gmo…
What does all of this mean? Does more expensive = better? Do I need organic or is that just a waste of money?
...After standing around trying to figure it out, your eyes start glazing over. Why is it so hard just to get some eggs?!
Making better food choices can be confusing. IT’S NOT YOUR FAULT. You see, food companies are really -- and we mean REALLY -- good at marketing.
“All natural” or “sugar-free” makes us feel like we are doing something better for ourselves & our families…
Well, most of the time, it’s one big fat lie...and you might just be wasting your money!
That is why we wanted to share this brand new “Clean Living Clarity” Guide with you from our friends Andrea & Ashley. Determined coaches frustrated by the marketing hogwash that have people just like you overwhelmed & confused.
...You can stop guessing, and start making better decisions right away!
When you grab this gift, you'll also save a seat for the free, online Breaking Up With Exhaustion Masterclass taking place October 26th-November 1st, -- where you will learn so much about REAL food, and much, much more... to help YOU find solutions to beat your exhaustion, once and for all.
To your health,
The Beyond Organic Doctors Team
P.S. Don't miss out on this resourceful eGuide, Clean Living Clarity… and shopping will never be overwhelming again!
You get to the egg section…
Cage-free…
Hormone free…
Vegetarian...
Organic…
Pasture raised…
Non-gmo…
What does all of this mean? Does more expensive = better? Do I need organic or is that just a waste of money?
...After standing around trying to figure it out, your eyes start glazing over. Why is it so hard just to get some eggs?!
Making better food choices can be confusing. IT’S NOT YOUR FAULT. You see, food companies are really -- and we mean REALLY -- good at marketing.
“All natural” or “sugar-free” makes us feel like we are doing something better for ourselves & our families…
Well, most of the time, it’s one big fat lie...and you might just be wasting your money!
That is why we wanted to share this brand new “Clean Living Clarity” Guide with you from our friends Andrea & Ashley. Determined coaches frustrated by the marketing hogwash that have people just like you overwhelmed & confused.
...You can stop guessing, and start making better decisions right away!
When you grab this gift, you'll also save a seat for the free, online Breaking Up With Exhaustion Masterclass taking place October 26th-November 1st, -- where you will learn so much about REAL food, and much, much more... to help YOU find solutions to beat your exhaustion, once and for all.
To your health,
The Beyond Organic Doctors Team
P.S. Don't miss out on this resourceful eGuide, Clean Living Clarity… and shopping will never be overwhelming again!
Gonna try this

Ingredients
- 1 cup frozen strawberries
- 3/4 cup blueberries
- 1/2 banana
- 1/2 cup frozen pineapple
- 2 cups spinach
- water to desired consistency
- 1 tbsp ground flax seed
Directions
- Blend all ingrediesnts on smoothie setting in Blendtec blender
- Serve immediately and enjoy!
Prep time: 10 min
Serves: 2
Enjoy!
spinach

Sent from....Somewhere on Tapatalk
I think they will enough, good for youGonna try this. Hoping, the fruits will cover up the taste of the spinach....
spinach
Sent from....Somewhere on Tapatalk
|
|
|
|
10 Lessons – 10 Years as a Breast Cancer and Autoimmune Survivor

 pinkfortitude.com
pinkfortitude.com

10 Lessons - 10 Years as a Breast Cancer and Autoimmune Survivor - Pink Fortitude, LLC
Little did I know how much life would change. And for the better. These are my 10 lessons in 10 years as a breast cancer and autoimmune survivor. Plus a love letter. I hope this gives you some encouragement with the health challenges you are going through!
| ||
| ||
| ||
| ||
|
|
|
|
| 6 Drug-Free Ways to Lower Cholesterol By Chauncey Crandall, M.D. Trying to find the right treatment plan for high cholesterol can be overwhelming, with a host of supplements and drug alternatives on the market claiming to be cure-alls. Special: Discover How Plant Sterols Can Help Lower Your Cholesterol Here are several supplements that can help with high cholesterol:
|
|
|
Dr. Carrie Madej warns about coronavirus vaccines and transhumanism nanotechnology to alter your DNA

 www.brighteon.com
www.brighteon.com

Dr. Carrie Madej warns about coronavirus vaccines and transhumanism nanotechnology to alter your DNA
For more updates, visit: http://www.brighteon.com/channel/hrreport Natural News videos would not be possible without you. As always we remain passionately dedicated to our mission of educating people all over the world on the subject of natural healing remedies and personal liberty (food...
Here’s the natural cure for Covid-19 the CDC does NOT want you to use

 www.naturalnews.com
www.naturalnews.com

Here’s the natural cure for Covid-19 the CDC does NOT want you to use – NaturalNews.com
Ready to exit “abnormal” and get back to the real normal, again? We all are. Introducing the nearly 100 percent successful, natural remedy for the new “C” word… coronavirus, a.k.a. Bill Gates disease. Doctors at a hospital in Ocala, Florida (AdventHealth) have a treatment for the dreaded...
Covid-19 vaccines cause trial participants to suffer day-long exhaustion, cracked teeth, headaches and high fever

 www.naturalnews.com
www.naturalnews.com

Covid-19 vaccines cause trial participants to suffer day-long exhaustion, cracked teeth, headaches and high fever – NaturalNews.com
Things are going exceptionally poorly for the four major drug companies rushing to be the first to introduce a vaccine for the Wuhan coronavirus (covid-19). Trial participants are reportedly coming down with all sorts of bizarre side effects that, quite honestly, sound far worse than what the...
Have you heard the term “Symptom Control Medicine,” Jim?
It refers to the unfortunate reality that most modern medicine involves treating symptoms rather than curing the root cause of illnesses.
But it doesn’t have to be this way.
Naturopathic doctor and global leader Christine Schaffner has made tremendous headway in the field of bioregulatory medicine and is proving that *actual healing* is possible for even the most complex and life-threatening conditions.
She recently held a speaker series for medical professionals that brought together the world’s foremost experts in this exciting field, where they took a deep collective dive into the science of getting TRULY healthy at the cellular level—once and for all.
The event was so well received that she’s decided to hold an Encore Weekend, October 3rd - 4th for both healthcare professionals AND the general public!
Click here to attend this powerful and informative FREE online event!>>
If you’re not familiar with bioregulatory medicine, it’s used extensively in Europe and is a customized, patient-centered model that combines centuries of traditional wisdom with leading-edge innovations to promote regulatory self-healing.
And what’s especially exciting about this encore event is that it’s tailored to healthcare workers, healers, and patients alike…
So whether you’re looking to foster your own deep healing or are helping clients or patients step into optimal health, you’ll learn volumes about what’s really possible!
Claim your FREE ticket now and discover the miracle of Bioregulatory Medicine!>>
To the new frontier of your health and wellness,
Laura Trumbull
Community Director
Evolving Wisdom
P.S. The patients Dr. Schaffner treats have usually been seen by at least 25 different doctors (and sometimes as many as 50!) before arriving at her office, and she’s found cures for mysterious chronic illnesses that no one else in modern medicine has been able to figure out. Tune in to hear her and these other world-renowned experts in her sphere who have had similar success!
Save your FREE seat now to this health-transforming encore event!>>
It refers to the unfortunate reality that most modern medicine involves treating symptoms rather than curing the root cause of illnesses.
But it doesn’t have to be this way.
Naturopathic doctor and global leader Christine Schaffner has made tremendous headway in the field of bioregulatory medicine and is proving that *actual healing* is possible for even the most complex and life-threatening conditions.
She recently held a speaker series for medical professionals that brought together the world’s foremost experts in this exciting field, where they took a deep collective dive into the science of getting TRULY healthy at the cellular level—once and for all.
The event was so well received that she’s decided to hold an Encore Weekend, October 3rd - 4th for both healthcare professionals AND the general public!
Click here to attend this powerful and informative FREE online event!>>
If you’re not familiar with bioregulatory medicine, it’s used extensively in Europe and is a customized, patient-centered model that combines centuries of traditional wisdom with leading-edge innovations to promote regulatory self-healing.
And what’s especially exciting about this encore event is that it’s tailored to healthcare workers, healers, and patients alike…
So whether you’re looking to foster your own deep healing or are helping clients or patients step into optimal health, you’ll learn volumes about what’s really possible!
Claim your FREE ticket now and discover the miracle of Bioregulatory Medicine!>>
To the new frontier of your health and wellness,
Laura Trumbull
Community Director
Evolving Wisdom
P.S. The patients Dr. Schaffner treats have usually been seen by at least 25 different doctors (and sometimes as many as 50!) before arriving at her office, and she’s found cures for mysterious chronic illnesses that no one else in modern medicine has been able to figure out. Tune in to hear her and these other world-renowned experts in her sphere who have had similar success!
Save your FREE seat now to this health-transforming encore event!>>
Your different types of body fat (and how to get rid of it)
Did you know that not all fats are created equal?
And no, we're not talking about olive oil vs. canola…
>> Body fat comes in different forms.
One type gives you love handles and maybe a little gut…
The other type —called visceral fat —is highly dangerous.
Visceral fat contributes to insulin resistance and inflammation, leading to all manner of metabolic diseases.
And the scariest part?
You don’t have to LOOK fat to have dangerous visceral fat around your organs… making even thin people susceptible to metabolic diseases like diabetes.
The good news is, there’s a way to make sure you’re burning all types of fat efficiently.
Eating the right types of fats play a crucial role in either supporting or harming your wellness journey.
>> Learn exactly what to eat to burn dangerous visceral fat that you can’t even see!
Today’s Recommendation from Beyond Organic Doctors
Do you suffer from dry skin, dandruff, or brittle fingernails?
You might think these symptoms run in your family, or just come with age…
In reality, they’re a side effect of a crucial nutrient deficiency —one that 95% of Americans suffer from.
And dry skin is just the beginning...
Chronic deficiency of this crucial nutrient could lead to inflammation, heart issues, and more.
It’s a fatty acid deficiency. And it’s more common than you think.
As adults, we need essential fatty acids like DHA and EPA for cardiovascular health, the structure of cell membranes, and to help lower inflammation.
The thing is... you’d have to eat fish several times per week just to make a dent in those fatty acids levels.
Until now.
>> Pure Form Omega is a patented mix of organic, plant-based essential fatty acids that convert to DHA and EPA in your body! Save 15% with promo code 'BODOMEG15' here now for a limited time only.
That’s right — ALL plants. No fishy smell or fish burps. And not a chance of mercury toxicity.
Still, you’ll get many of the same benefits you’d get from expensive fish oil. Benefits like:
>> Get the benefits of all-natural, plant-based fatty acids with Pure Form Omega.
To your health,
The Beyond Organic Doctors Team
Did you know that not all fats are created equal?
And no, we're not talking about olive oil vs. canola…
>> Body fat comes in different forms.
One type gives you love handles and maybe a little gut…
The other type —called visceral fat —is highly dangerous.
Visceral fat contributes to insulin resistance and inflammation, leading to all manner of metabolic diseases.
And the scariest part?
You don’t have to LOOK fat to have dangerous visceral fat around your organs… making even thin people susceptible to metabolic diseases like diabetes.
The good news is, there’s a way to make sure you’re burning all types of fat efficiently.
Eating the right types of fats play a crucial role in either supporting or harming your wellness journey.
>> Learn exactly what to eat to burn dangerous visceral fat that you can’t even see!
Today’s Recommendation from Beyond Organic Doctors
Do you suffer from dry skin, dandruff, or brittle fingernails?
You might think these symptoms run in your family, or just come with age…
In reality, they’re a side effect of a crucial nutrient deficiency —one that 95% of Americans suffer from.
And dry skin is just the beginning...
Chronic deficiency of this crucial nutrient could lead to inflammation, heart issues, and more.
It’s a fatty acid deficiency. And it’s more common than you think.
As adults, we need essential fatty acids like DHA and EPA for cardiovascular health, the structure of cell membranes, and to help lower inflammation.
The thing is... you’d have to eat fish several times per week just to make a dent in those fatty acids levels.
Until now.
>> Pure Form Omega is a patented mix of organic, plant-based essential fatty acids that convert to DHA and EPA in your body! Save 15% with promo code 'BODOMEG15' here now for a limited time only.
That’s right — ALL plants. No fishy smell or fish burps. And not a chance of mercury toxicity.
Still, you’ll get many of the same benefits you’d get from expensive fish oil. Benefits like:
- Decreased inflammation
- Balances hormones
- Supports heart health
- Protects brain function
- Helps reduce joint pain
- Supports healthy, vibrant skin
>> Get the benefits of all-natural, plant-based fatty acids with Pure Form Omega.
To your health,
The Beyond Organic Doctors Team
Study Reveals What Protects Against Colon Cancer

 www.newsmax.com
www.newsmax.com
Study Reveals What Protects Against Colon Cancer
Certain nutrients, foods, and medicines may help protect you against colon cancer, a large research review suggests.
Hi Jimi,
Ever wonder why things like bacon, salmon, sausage, and hot dogs stay pink for so long?
It’s not natural.
Manufacturers use unhealthy food additives to achieve a specific color.
The ones that they add to hot dogs are nitrates and nitrites — they’re preservatives that make food look pretty, but they can turn harmful once inside your gut. (1)
The next time you eat a hot dog, or anything else that may have food preservatives, eat this afterward.
It’s a blend of green foods and Chinese herbs that can help discourage too many of these preservatives from getting absorbed by your body.
Taking it before or after any “questionable” meals can do a lot for your liver, kidney, and gut — stopping these chemicals from building up in your fat cells and organ tissue.
Hot dogs aren’t the only reason I encourage you to try it.
Preservatives are just some of the food additives that you need to watch out for.
The EWG just released a list of 12 harmful food additives — calling them the “dirty dozen”. (1)
Here’s what you should try and avoid:
These food additives can be found in hundreds of foods — too long to list.
Government agencies allow their use despite evidence that they may be harmful to human health.
Avoiding them is getting harder and harder.
You can’t trust that everything you’re going to eat won’t contain some of these.
Ever wonder why things like bacon, salmon, sausage, and hot dogs stay pink for so long?
It’s not natural.
Manufacturers use unhealthy food additives to achieve a specific color.
The ones that they add to hot dogs are nitrates and nitrites — they’re preservatives that make food look pretty, but they can turn harmful once inside your gut. (1)
The next time you eat a hot dog, or anything else that may have food preservatives, eat this afterward.
It’s a blend of green foods and Chinese herbs that can help discourage too many of these preservatives from getting absorbed by your body.
Taking it before or after any “questionable” meals can do a lot for your liver, kidney, and gut — stopping these chemicals from building up in your fat cells and organ tissue.
Hot dogs aren’t the only reason I encourage you to try it.
Preservatives are just some of the food additives that you need to watch out for.
The EWG just released a list of 12 harmful food additives — calling them the “dirty dozen”. (1)
Here’s what you should try and avoid:
- NITRITES AND NITRATES (found in cured meats)
- POTASSIUM BROMATE (found in bread and crackers)
- PROPYLPARABEN (found in tortillas and muffins)
- BUTYLATED HYDROXYANISOLE (found in chips and meats)
- BUTYLATED HYDROXYTOLUENE (found in cereal)
- PROPYL GALLATE (found in sausage and animal fats)
- THEOBROMINE (found in chocolate, bread, and sports drinks)
- SECRET FLAVOR INGREDIENTS (present in over 80,000 foods)
- ARTIFICIAL COLORS (also present in thousands of foods)
- DIACETYL (found in yogurt, cheese, flavored dairy products, and popcorn)
- PHOSPHATE FOOD ADDITIVES (found in over 20,000 foods)
- ALUMINUM ADDITIVES (found in bread, cake mix, tea, flour, salt and more)
These food additives can be found in hundreds of foods — too long to list.
Government agencies allow their use despite evidence that they may be harmful to human health.
Avoiding them is getting harder and harder.
You can’t trust that everything you’re going to eat won’t contain some of these.
Dear Jimi,
I just received this and wanted to pass it along...
Here’s a {video) preview of “The Truth About Vaccines 2020” docu-series which starts Tue. Oct. 13.
Click Here to Watch This Important Event
I know Ty and Charlene Bollinger - big time supporters of our work here at NaturalHealth365 - will be offering 10 days of amazing content, and I’m so excited to watch this event with you.
No doubt, this topic is heating up in the halls of Congress right now, with the C-Virus vaccine being “fast-tracked” and so many people (including doctors!) voicing their concerns about the safety and effectiveness of this rushed-to-market "solution.".
Keep in mind, this docu-series will be packed with NEW, helpful information about his topic that I know will make a difference for you and your family.
No matter what your position is on vaccines, I strongly encourage you to request access to this complimentary event NOW.
It’s not about being “pro” or “anti” anything ... it’s about getting the facts (and the full story that’s not being told), and understanding what all your options are.
Taking the time to get educated and get the facts will bring you greater peace and confidence, knowing how to best care for yourself and your family and keep them safe from harm.
>>> Click Here to Watch This Event Today <<<
Keep your immune system healthy and strong,
-Jonathan Landsman
NaturalHealth365
PS: Share this link with family and friends, so they can get complimentary access to The Truth About Vaccines. This event will truly help to save lives.
I just received this and wanted to pass it along...
Here’s a {video) preview of “The Truth About Vaccines 2020” docu-series which starts Tue. Oct. 13.
Click Here to Watch This Important Event
I know Ty and Charlene Bollinger - big time supporters of our work here at NaturalHealth365 - will be offering 10 days of amazing content, and I’m so excited to watch this event with you.
No doubt, this topic is heating up in the halls of Congress right now, with the C-Virus vaccine being “fast-tracked” and so many people (including doctors!) voicing their concerns about the safety and effectiveness of this rushed-to-market "solution.".
Keep in mind, this docu-series will be packed with NEW, helpful information about his topic that I know will make a difference for you and your family.
No matter what your position is on vaccines, I strongly encourage you to request access to this complimentary event NOW.
It’s not about being “pro” or “anti” anything ... it’s about getting the facts (and the full story that’s not being told), and understanding what all your options are.
Taking the time to get educated and get the facts will bring you greater peace and confidence, knowing how to best care for yourself and your family and keep them safe from harm.
>>> Click Here to Watch This Event Today <<<
Keep your immune system healthy and strong,
-Jonathan Landsman
NaturalHealth365
PS: Share this link with family and friends, so they can get complimentary access to The Truth About Vaccines. This event will truly help to save lives.
Can Too Much TV Give You a Blood Clot?
By Chauncey Crandall, M.D.
A recent study found that people who spend too much time in front of the TV are at increased risk for blood clots in their veins — a condition called venous thromboembolism (VTE).
These clots often occur in the legs and can dislodge and travel to the lungs, causing a potentially deadly condition called pulmonary embolism.
Special: 4 Signs Your Heart Is Quietly Failing
As University of Minnesota researchers explained, sitting for long periods of time can cause blood clots to form, because normal circulation through the legs and feet is impaired.
So, could prolonged TV viewing raise the risk? To find out, the researchers analyzed data from more than 15,000 Americans, aged 45 to 64, in a long-term study that began in 1987.
As of 2011, nearly 700 cases of VTE had occurred among the participants. Those who watched a lot of television had a 70% higher risk of developing one of the clots than people who never or seldom watched TV.
This risk remained high even after factors such as the person's weight or exercise levels were taken into account.
By Chauncey Crandall, M.D.
A recent study found that people who spend too much time in front of the TV are at increased risk for blood clots in their veins — a condition called venous thromboembolism (VTE).
These clots often occur in the legs and can dislodge and travel to the lungs, causing a potentially deadly condition called pulmonary embolism.
Special: 4 Signs Your Heart Is Quietly Failing
As University of Minnesota researchers explained, sitting for long periods of time can cause blood clots to form, because normal circulation through the legs and feet is impaired.
So, could prolonged TV viewing raise the risk? To find out, the researchers analyzed data from more than 15,000 Americans, aged 45 to 64, in a long-term study that began in 1987.
As of 2011, nearly 700 cases of VTE had occurred among the participants. Those who watched a lot of television had a 70% higher risk of developing one of the clots than people who never or seldom watched TV.
This risk remained high even after factors such as the person's weight or exercise levels were taken into account.
Did you already sign up for the Plant Fit Summit, Jim?
It starts today!
I know that my friends and colleagues Luke and Tobi are going to start the summit with a ton of incredible content so make sure to sign-up right now or you may miss some of the best presentations...
>> Sign up here
Everyday you’ll master a different aspect of well-being with 3 to 4 brand new presentations!
There are a number of exciting topics being presented, but here are a few of the ones I recommend:
Join now and watch from anywhere in the world!
See you there!
P.S. Maybe you haven’t heard about the Plant Fit Summit yet? It's the only online event where leading doctors, elite athletes, world-class coaches and people who've been in your shoes are coming together to help YOU!
Whether you want to lose weight, gain muscle, perform at an elite level, set world records or simply wake up with energy and health every day, this is for you!
Click here to register now.
It starts today!
I know that my friends and colleagues Luke and Tobi are going to start the summit with a ton of incredible content so make sure to sign-up right now or you may miss some of the best presentations...
>> Sign up here
Everyday you’ll master a different aspect of well-being with 3 to 4 brand new presentations!
There are a number of exciting topics being presented, but here are a few of the ones I recommend:
- How animal protein impacts our immunity and a new look at Vitamin D
- The hormone key: how food impacts our every cell
- How to overcome fear and find your inner truth
- Avoiding pitfalls that may limit your fitness and performance on a plant based diet
- Simplifying and optimizing nutrition (plus the fasting reset)
Join now and watch from anywhere in the world!
See you there!
P.S. Maybe you haven’t heard about the Plant Fit Summit yet? It's the only online event where leading doctors, elite athletes, world-class coaches and people who've been in your shoes are coming together to help YOU!
Whether you want to lose weight, gain muscle, perform at an elite level, set world records or simply wake up with energy and health every day, this is for you!
Click here to register now.
| |||||
| |||||
|
| What nightmares do to your body |
| Turns out that nightmares cause a lot more harm than just a bad night's sleep. Latest studies show nightmares trigger a cascade of physiological responses that immediately weakens the immune system and signals the body to store fat in the belly region for days. Interestingly enough, studies show your body interprets a nightmare as a severe form of stress and it simply reacts accordingly. For starters, this subconscious stress forces the release of your fat-storing hormone cortisol while simultaneously suppressing hormones that regulate your appetite. Which is a terrible combination when it comes to your health and fitness goals... And if you've ever found yourself extra hungry or losing a food cravings battle the day after a bad night's sleep, now you know why. Fact is, the negative impact that nightmares, or even just a poor night's sleep can have on the body is quite fascinating... YET, the reverse is also true. Enjoying a good night's sleep, or more specifically - enjoying 1 specific kind of sleep has been proven to boost our immune system, fend off signs of aging, and even help us to burn more fat... Which is why I urge you to take 2 minutes to make one tiny change to your bedtime routine, which you'll see at the link below. This tiny little tweak to your bedtime routine prepares your body for a perfect night's sleep and promotes your body to release stored belly fat while you sleep instead of storing it. >> Make This Tiny Change To Your Bedtime Routine Tonight |
The 7 Best Ways for Balancing Your Hormones Naturally

 yurielkaim.com
yurielkaim.com

The 7 Best Ways for Balancing Your Hormones Naturally | Yuri Elkaim
Cranky, bloated, tired: when one hormone gets out of whack, they all do. Here's what you can do to regain control and start feeling like yourself again.
nadalama
Senior Moderator
Staff member
Senior Moderator
VU Donator
Diamond Contributor
Member For 4 Years
VU Patreon
Do people get much value from this thread?
What a rude thing to say! I am gobsmacked!

Thank you my friend. I guess some don't realize iI do this just to help others and so they will see the natural side of medicine.What a rude thing to say! I am gobsmacked!